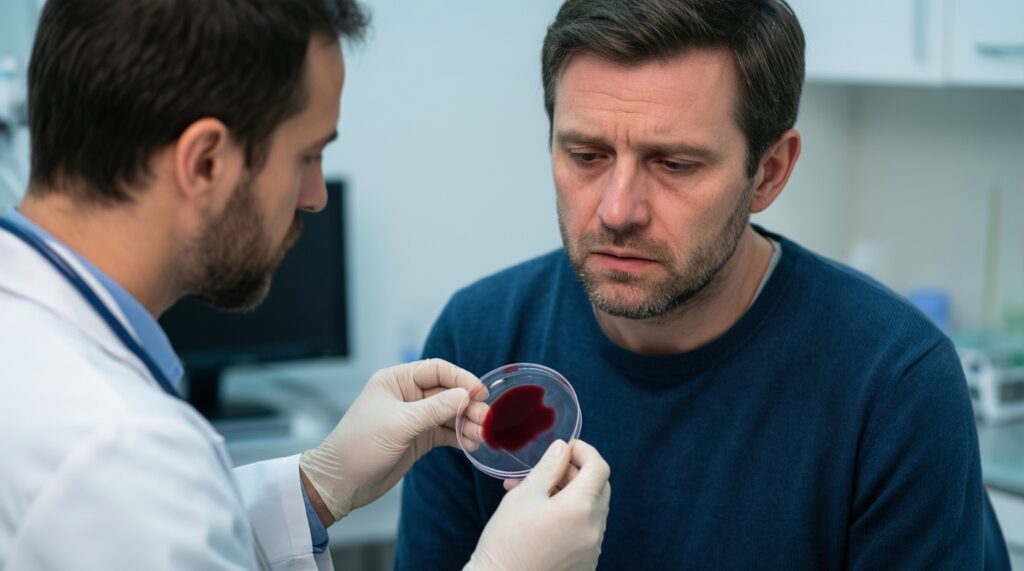
Мужское здоровье: урологические симптомы, которые нельзя игнорировать - иллюстрация

Урологические симптомы у мужчин - это изменения мочеиспускания, боли, выделения, кровь в моче/эякуляте, проблемы с эрекцией и острые состояния в мошонке, которые могут указывать на инфекцию, обструкцию, камни или опухоль. Практичное правило: оцените срочность, не маскируйте симптом обезболивающими и организуйте осмотр уролога с базовыми анализами.
Сигналы, которые нельзя пропустить
- Острая боль в яичке/мошонке, быстрый отёк, тошнота - повод ехать в неотложку, а не ждать.
- Невозможность помочиться при позывах или резкое падение струи - риск острой задержки мочи.
- Кровь в моче (даже однократно), особенно без боли - всегда требует обследования.
- Жжение при мочеиспускании с выделениями из уретры - вероятна инфекция, часто передающаяся половым путём.
- Лихорадка + боль в промежности/пояснице + частое мочеиспускание - возможна восходящая инфекция, нужен врач в ближайшие сутки.
- Стойкое ухудшение эрекции/либидо на фоне сосудистых факторов и стресса - повод проверить не только урологию, но и общий метаболический риск.
Наружные урологические проявления: боль, отёк, выделения
К наружным проявлениям относят симптомы со стороны полового члена, уретры, мошонки и области промежности: боль, покраснение, отёк, уплотнения, язвочки, зуд, а также выделения из уретры. Их важно отличать от кожных проблем (дерматит, грибок), но на практике граница размыта: уролог часто работает вместе с дерматовенерологом.
Самые частые причины - инфекции (в том числе ИППП), воспаление придатка яичка/яичка, травма, обострение хронического простатита, реже - новообразования. Характер симптома помогает с маршрутом: гнойные выделения и жжение чаще про уретрит, локальная болезненная "шишка" в мошонке - про воспаление/кисту, безболезненное уплотнение в яичке - требует исключать опухоль.
Что обычно назначают на первичном этапе: осмотр, мазок/ПЦР по показаниям, общий анализ мочи, посев мочи или отделяемого, УЗИ мошонки с допплером при боли/отёке, иногда - анализы крови при температуре.
- До визита: не выдавливайте и не прижигайте "прыщи", не начинайте антибиотик "наугад" - это смазывает картину.
- Если есть отёк мошонки и сильная боль: срочно обращайтесь за неотложной помощью.
- Если выделения/жжение: запланируйте осмотр и диагностику, партнёру(ам) может потребоваться обследование.
Проблемы мочеиспускания: затруднение, частота, боль
Механика симптомов обычно сводится к трём узлам: воспаление слизистой (боль/жжение), препятствие оттоку (слабая струя, натуживание, неполное опорожнение), и "раздражение" мочевого пузыря (частые позывы, ночные подъёмы). На одном и том же фоне симптомы могут сочетаться, поэтому важнее описывать конкретику, чем пытаться ставить диагноз по одному признаку.
- Слабая струя, паузы, натуживание - часто при увеличении простаты, стриктуре уретры, реже при неврологических нарушениях.
- Частые позывы, особенно ночью - возможны гиперактивность мочевого пузыря, воспаление, влияние кофеина/алкоголя, декомпенсация диабета.
- Боль/жжение - чаще уретрит/цистит, иногда камень в нижних отделах.
- Ощущение неполного опорожнения - признак остаточной мочи; важно оценить риск задержки.
- Внезапные императивные позывы - иногда "маска" инфекции или камня, иногда - функциональная проблема.
- Подтекание - бывает при переполнении пузыря (опасный вариант) или при нарушении сфинктерного контроля.
На практике пациенты часто ищут "лечение аденомы простаты стоимость" или "лечение простатита у мужчин цена" ещё до диагностики. Правильнее сначала определить механизм (воспаление vs обструкция vs нейрогенный компонент): от этого зависят и тактика, и объём обследований, и итоговая стоимость лечения.
- В ближайшие сутки: обратитесь к врачу, если есть температура, боль в боку/пояснице, выраженная слабость или кровь в моче.
- Планово: фиксируйте 2-3 дня частоту мочеиспусканий/ночных подъёмов и объём жидкости - это помогает урологу быстрее разобраться.
- Срочно: если не можете помочиться при сильных позывах - вызывайте скорую/едьте в стационар.
Гематурия и гематоспермия: оценка риска
Гематурия - кровь в моче (видимая или только по анализу). Гематоспермия - кровь в эякуляте. Эти симптомы не всегда означают "что-то страшное", но и игнорировать их нельзя: подход зависит от контекста, возраста, боли, температуры, повторяемости и сопутствующих факторов.
- Кровь в моче без боли - требует исключить опухолевые причины и источник кровотечения по мочевым путям.
- Кровь + резь/частые позывы - чаще воспаление, но обследование всё равно нужно, особенно если эпизод повторяется.
- Кровь после физнагрузки - возможен "триггер" на фоне камня/воспаления; нельзя списывать только на нагрузку.
- Гематоспермия после длительного воздержания/активной половой жизни - нередко доброкачественно, но при повторении нужна диагностика простаты/семенных пузырьков.
- Кровь на фоне антикоагулянтов - лекарства могут усилить кровотечение, но не объясняют источник; обследование обязательно.
Частый запрос "анализы при урологических заболеваниях у мужчин цена" закономерен: обычно стартуют с общего анализа мочи, микроскопии осадка, иногда - посева, анализа крови по ситуации и визуализации (УЗИ/КТ по показаниям). Объём определяют после осмотра и уточняющих вопросов.
- Не откладывайте: видимая кровь в моче - повод для обращения к урологу в ближайшие дни, даже если "уже прошло".
- Подготовьтесь: сфотографируйте цвет мочи/сгустки (без публикаций), запишите лекарства (включая аспирин и антикоагулянты).
- Исключите самоназначения: не начинайте кровоостанавливающие и антибиотики без врача.
Падение эрекции и изменение либидо как показатель общего здоровья
Эректильная дисфункция и снижение либидо - не только про сексуальную функцию. Часто это маркер сосудистых проблем, эндокринных сдвигов, хронического стресса, нарушений сна, побочных эффектов лекарств. Поэтому урологическая оценка нередко дополняется кардиометаболическим скринингом.
Что полезно в таком "симптоме-маркере"
- Помогает выявить факторы риска: курение, гиподинамия, лишний вес, гипертония, дислипидемия, нарушения углеводного обмена.
- Позволяет не пропустить локальные причины: воспаление простаты, гормональные нарушения, побочные эффекты препаратов.
- Даёт понятную точку контроля: динамика на фоне изменения образа жизни и лечения.
Ограничения и частые ошибки интерпретации

- Нельзя "назначить себе" терапию по одному симптому: одинаковая жалоба имеет разные причины.
- Психогенный компонент реален, но диагноз "от нервов" ставят после исключения медицинских причин.
- Запрос "лечение эректильной дисфункции у мужчин цена" без диагностики почти всегда преждевременный: стоимость зависит от причин и объёма обследования.
- Запишите контекст: когда началось, утренние эрекции, связь со стрессом/алкоголем/лекарствами.
- Сделайте первый шаг: плановый визит к урологу и базовые анализы по показаниям.
- Не смешивайте препараты: не комбинируйте средства "для потенции" без назначения врача.
Неотложные состояния: острый эпидидимит, перекрут яичка, задержка мочи
Неотложные урологические ситуации опасны тем, что "окно времени" может быть коротким, а самолечение - ухудшает прогноз. Ключ - распознать сценарий, не тратить часы на форумы и не пытаться "перетерпеть".
- Миф: "Если боль в яичке терпимая, можно подождать до завтра". Ошибка: при перекруте счёт идёт на часы, а боль бывает разной интенсивности.
- Миф: "Согрею - пройдёт". Ошибка: тепло может усилить отёк и распространение инфекции.
- Миф: "Если моча не идёт, выпью мочегонное". Ошибка: при обструкции это повышает давление и боль, не решая проблему.
- Миф: "Антибиотик из домашней аптечки - универсально". Ошибка: неправильный выбор и дозировка осложняют диагностику и лечение.
- Миф: "Боль в паху - это точно спина/мышца". Ошибка: так маскируются камень, воспаление, патология мошонки.
- Немедленно: внезапная боль и отёк мошонки, тошнота, асимметрия - вызывайте скорую/в приёмный покой.
- Немедленно: невозможность помочиться при сильных позывах - это неотложное состояние.
- До врача: не грейте, не пейте алкоголь, не принимайте антибиотики без назначения.
Порядок обследования и что делать до визита к врачу
План действий проще, чем кажется: описать симптом точно, оценить срочность, собрать минимум данных и попасть на осмотр. Если нужен "уролог для мужчин запись на прием", старайтесь выбрать ближайшее доступное окно при тревожных признаках, а при неотложности - не заменять им вызов скорой.
Мини-алгоритм принятия решений
- Отметьте красные флаги: острая боль в мошонке, задержка мочи, видимая кровь, высокая температура с ознобом, сильная боль в боку.
- Если красный флаг есть - обращайтесь в неотложную помощь.
- Если красных флагов нет - плановый визит к урологу в ближайшие дни, без самолечения антибиотиками.
- Подготовьте данные: список лекарств, аллергии, перенесённые ИППП/операции, начало и динамика симптомов, дневник мочеиспусканий (если актуально).
Короткий пример (мини-кейс)
Ситуация: мужчина отмечает учащённые ночные подъёмы и слабую струю без температуры и без крови. Действия: (1) дневник мочеиспусканий 2-3 дня, (2) общий анализ мочи до визита, (3) плановый приём уролога для оценки простаты и исключения остаточной мочи; обсуждение тактики уже после диагностики, а не по запросу "лечение аденомы простаты стоимость".
- До визита: не ограничивайте резко воду "чтобы реже бегать" - это может ухудшить самочувствие и исказить картину.
- Возьмите с собой: результаты прошлых УЗИ/анализов и перечень препаратов.
- Если состояние меняется в худшую сторону (боль, температура, кровь) - повышайте срочность обращения.
Самопроверка перед тем, как откладывать визит
- Я могу чётко описать симптом (когда, где, как часто, что усиливает/уменьшает), а не только "что-то не так".
- Я проверил красные флаги и понимаю, нужна ли неотложная помощь.
- Я не начал антибиотики/сильные обезболивающие без назначения, чтобы не смазать диагностику.
- Я подготовил минимум данных (лекарства, аллергии, анализы/УЗИ, дневник при необходимости).
- Я готов обсудить с врачом обследование и план, а вопросы цены (например, "анализы при урологических заболеваниях у мужчин цена") - уже после определения нужного объёма.
Короткие ответы на типичные сомнения пациентов
Можно ли подождать, если кровь в моче была один раз и прошла?
Нет, даже однократная гематурия требует обследования, потому что источник кровотечения может быть значимым. Срочность зависит от сопутствующих симптомов, но откладывать на месяцы нельзя.
Жжение при мочеиспускании - это всегда простатит?
Нет, чаще это уретрит или цистит, иногда - камень или раздражение слизистой. Диагноз ставят по осмотру и анализам, а не по одному ощущению.
Если нет температуры, инфекцию можно исключить?

Нельзя: часть урологических инфекций протекает без лихорадки. Температура повышает срочность, но её отсутствие не отменяет диагностику.
Когда проблема с эрекцией - это повод идти к урологу, а не к психологу?
Если нарушение стойкое, повторяется, есть сосудистые факторы риска или появились урологические симптомы, начните с уролога. Психологическая помощь может быть параллельной, но не вместо медицинского исключения причин.
Нужно ли сдавать анализы до приёма или лучше после?
Если есть возможность, базовый общий анализ мочи до визита часто полезен. Остальные исследования лучше делать по назначению, чтобы не платить за лишнее и не сдавать "не то".
Что делать, если ночью часто встаю в туалет, но днём терпимо?
Сделайте дневник мочеиспусканий и оцените вечерние триггеры (кофеин, алкоголь, поздняя жидкость), затем планово обратитесь к урологу. Ночные симптомы часто связаны с простатой, но причин несколько.
Как корректно обсуждать стоимость лечения на приёме?
Просите врача сначала сформулировать диагноз/рабочие версии и минимально достаточный план обследования, а затем - варианты лечения и ориентиры по затратам. Так запросы вроде "лечение простатита у мужчин цена" будут привязаны к вашей ситуации, а не к усреднённым ожиданиям.



